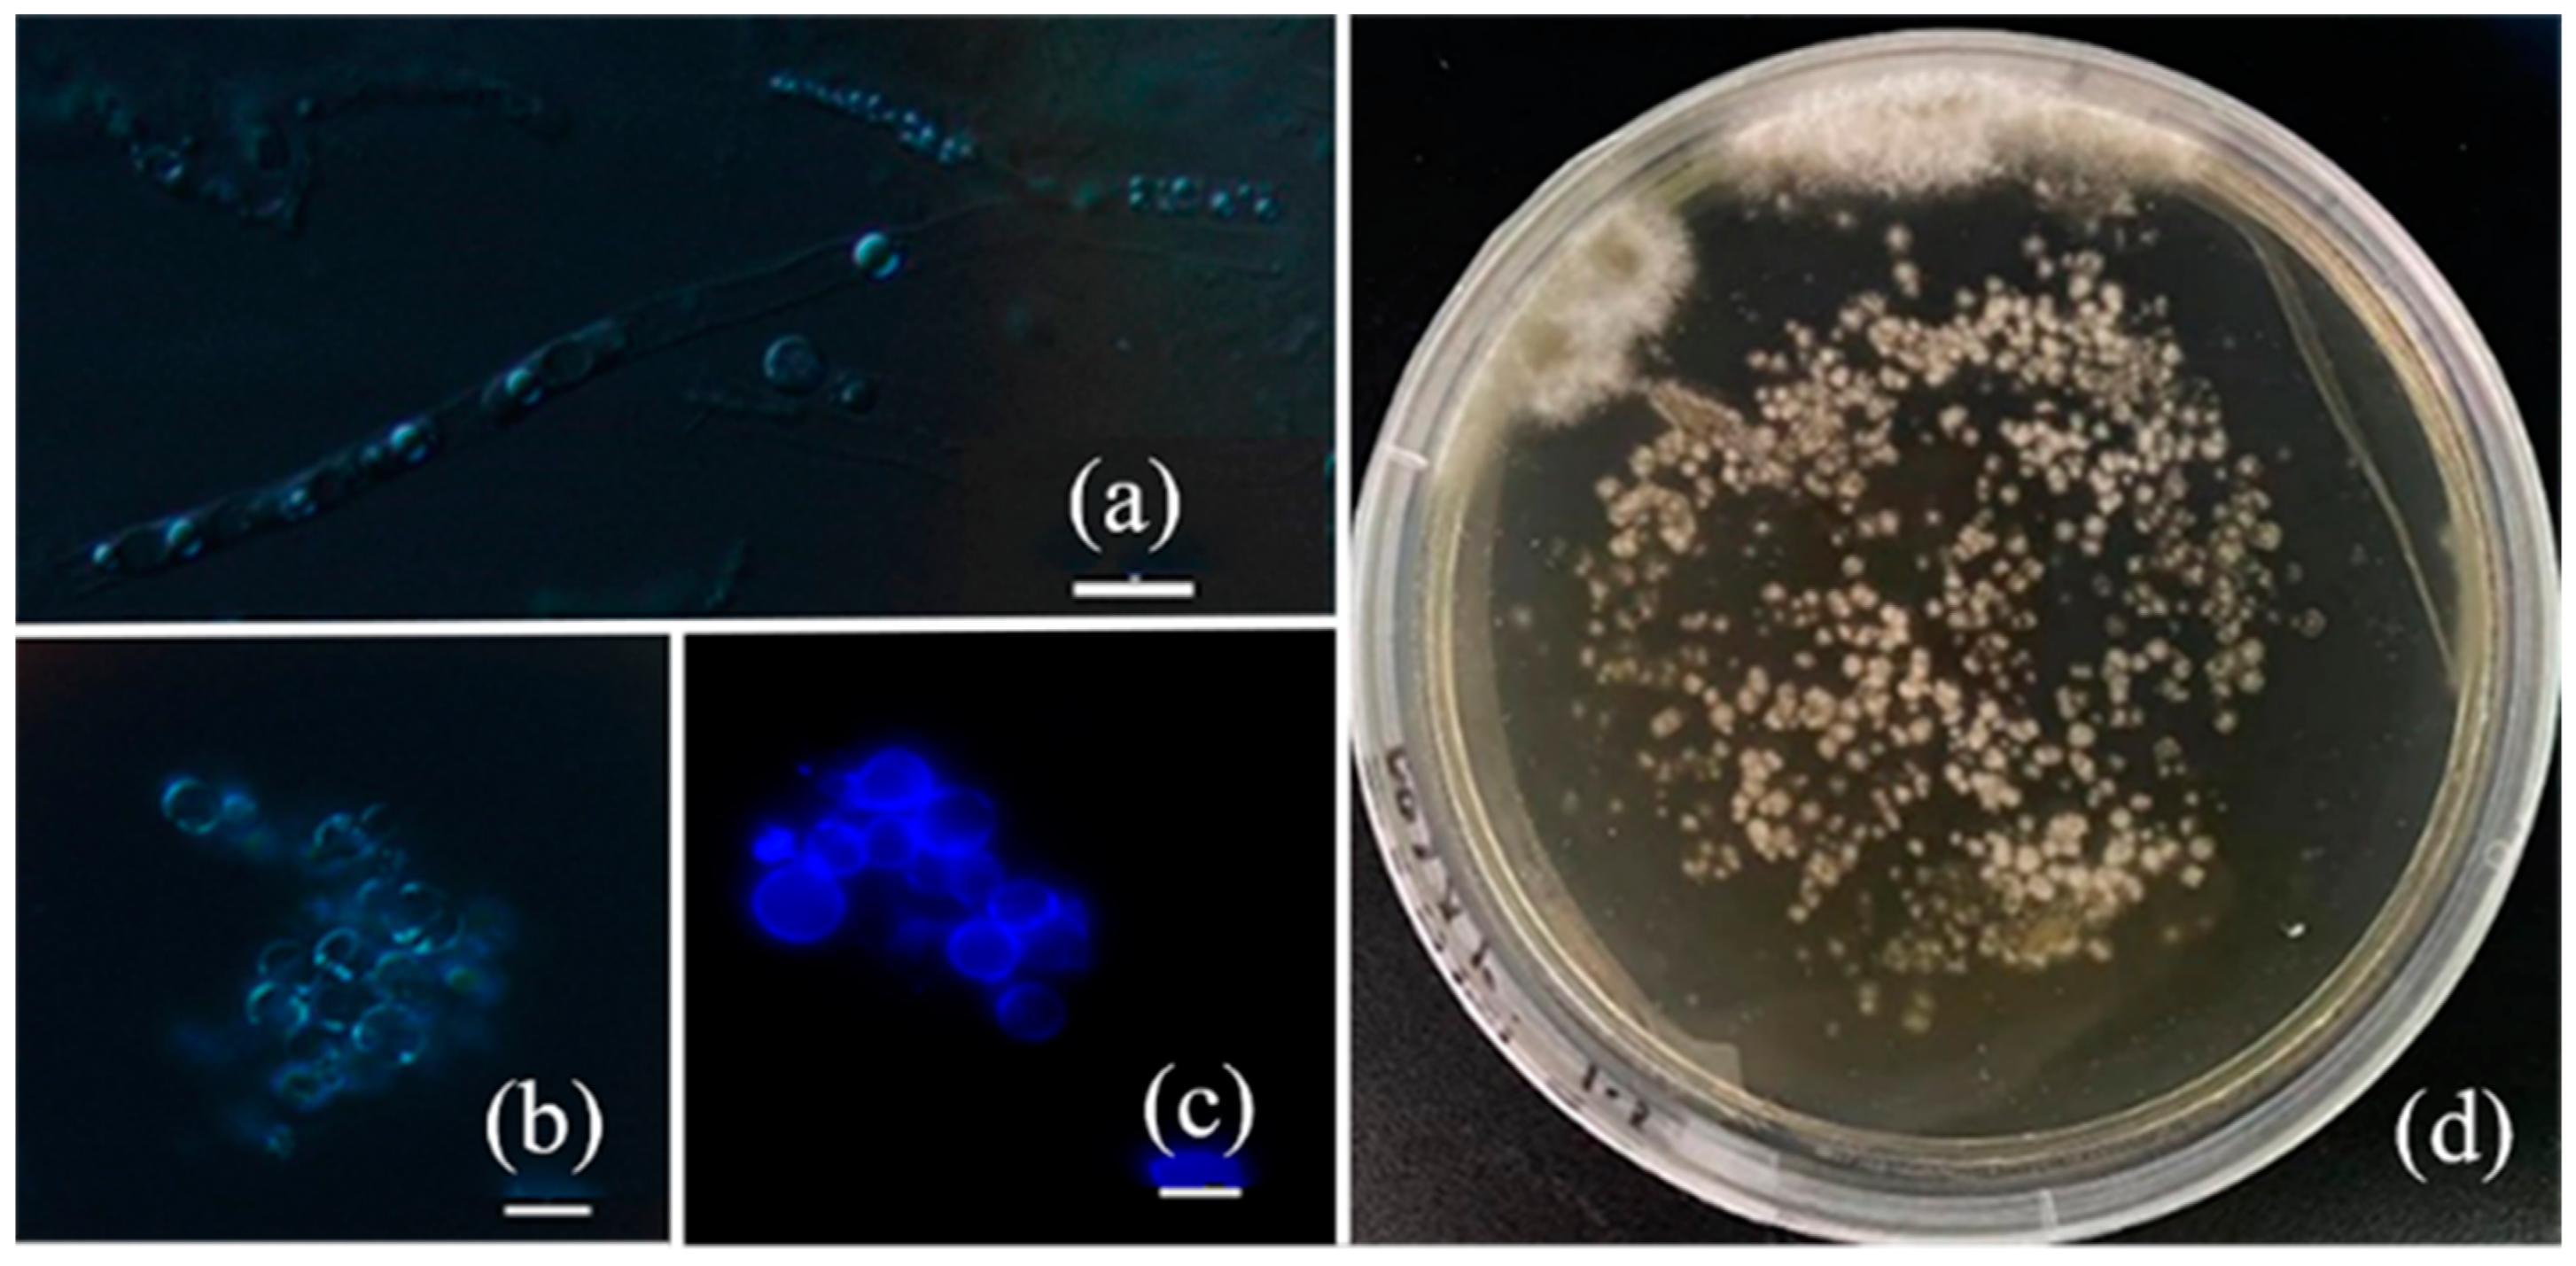
Microorganisms 12 01335 g001

Abstract
Inonotus obliquus, a medicinal fungus, has garnered significant attention in scientific research and medical applications. In this study, protoplasts of the I. obliquus HS819 strain were prepared using an enzymatic method and achieved a regeneration rate of 5.83%. To enhance polysaccharide production of I. obliquus HS819, atmospheric and room temperature plasma (ARTP) technology was employed for mutagenesis of the protoplasts. Through liquid fermentation, 32 mutant strains exhibiting diverse characteristics in morphology, color of the fermentation broth, mycelial pellet size, and biomass were screened. Secondary screening identified mutant strain A27, which showed a significant increase in polysaccharide production up to 1.67 g/L and a mycelial dry weight of 17.6 g/L, representing 137.67% and 15% increases compared to the HS819 strain, respectively. Furthermore, the fermentation period was reduced by 2 days, and subsequent subculture cultivation demonstrated stable polysaccharide production and mycelial dry weight. The genome resequencing analysis of the HS819 strain and mutant strain A27 revealed 3790 InDel sites and mutations affecting 612 functional genes associated with polysaccharide synthesis. We predict that our findings will be helpful for high polysaccharide production through genetic engineering of I. obliquus.
1. Introduction
Inonotus obliquus, a rare medicinal fungus, has become a valuable resource in the pharmaceutical and functional food industries. The fungus contains various bioactive substances, including triterpenoids, polysaccharides, steroids, polyphenols, and melanin [1]. Polysaccharides show a wide range of therapeutic potential, including anticancer [2], hypoglycemic [3], anti-inflammatory [4], antioxidant [5], anti-fatigue [6], and antiviral [7] activities. Although extensive research has been conducted on I. obliquus polysaccharides, current studies on improving polysaccharide production and biomass have mainly focused on optimizing the composition of culture media and fermentation conditions, including carbon source optimization [8], the addition of inducers [9], and controlling the aeration rate [10]. However, these methods have limited effectiveness and high costs. Modern genetic engineering technologies have been widely applied in microbial breeding, but these are severely limited by the unknown genetic backgrounds of the experimental strains. Random mutagenesis techniques have shown significant advantages in microbial improvement and breeding. They do not rely on host cell genetic information and can generate mutant libraries with genetic diversity. This is relatively simple and cost-effective [11]. Random mutagenesis methods include chemical mutagenesis, such as diethyl sulfate (DES) [12] and N-methyl-N’-nitro-N-nitrosoguanidine (NTG) [13], as well as physical mutagenesis, such as ultraviolet (UV) radiation [14] and Co60-γ rays [15]. However, these conventional methods may cause potential permanent harm to the environment and to users [16]. Atmospheric and room temperature plasma (ARTP) technology, as a novel physical mutagenesis method, has been successfully applied to generate various fungal mutants, owing to its advantages of easy operation, high safety, high mutagenic throughput, high total and positive mutation rates, and high genetic stability of mutants [17], such as Phellinus baumii [18], Grifola frondosa [19], and Chlorella pyrenoidosa [20]. ARTP can penetrate cell walls and membranes, causing maximum DNA damage to individual cells while maintaining cell viability, thereby inducing mutations and altering metabolism [21,22]. It operates at room temperature (25–40 °C), thus avoiding potential heat damage to thermosensitive microorganisms. This study represents the first attempt to utilize ARTP-induced mutants to enhance the polysaccharide productivity of I. obliquus.
Fungal protoplasts, as single-cell materials for mutagenesis breeding, can improve breeding efficiency. For example, Zhang et al. [23] utilized ARTP technology to treat the protoplasts of Pleurotus djamor. Through liquid shake flask fermentation of the high laccase-producing positive mutants, mutant strain 51-4 with the highest Lac activity of 494.44 U/L was identified, representing an 86.36% increase compared to the wild-type strain, with superior growth and genetic stability. In another study, a superior strain M27, with a 25.3% increase in gibberellic acid production (2.38 g/L), was obtained by co-mutagenizing the protoplasts of Fusarium fujikuroi using ARTP and EMS (ethyl methanesulfonate) methods, maintaining high yields over 10 generations [24,25]. Currently, there are few reports on mutagenesis breeding of I. obliquus, mainly using mycelia as the mutagenic material [26]. However, direct mutagenesis of mycelium cells is not ideal, due to the protective effect of the cell wall, limited DNA damage, and effective self-repair for achieving desirable mutational effects and obtaining pure mutant strains, with no reported methods for spore production and collection under indoor conditions. Protoplasts, with only a cell membrane that is more susceptible to mutagenic agent damage, can partially replace spores, offering the potential to obtain high-producing polysaccharide-positive mutants.
Currently, the analysis of the structure and functional activities of polysaccharides from I. obliquus is continuously deepening. However, little research has been conducted on the key regulatory genes or enzymes involved in the biosynthesis of polysaccharides in I. obliquus. With the advent of the post-genomic era, omics technologies, including genomics, transcriptomics, and proteomics, have been widely applied to edible microorganisms to reveal the biosynthesis and regulation of intracellular polysaccharides, laying the foundation for the high production of active polysaccharides and the development of products [27]. For example, Wu et al. [28] discovered through RNA-seq analysis that MAPK, amino sugar and nucleotide sugar metabolism, peroxisomes, starch and sucrose metabolism, TCA cycle, glycolysis/gluconeogenesis KEGG pathway, glycosyltransferases, glycoside hydrolases and autophagy, and ubiquitin-mediated protein degradation play important roles in enhancing the production of extracellular polysaccharides in the Ganoderma lucidum Tween 80-treated group. Lin et al. [29] demonstrated through transcriptomic analysis that cpsA is a key gene involved in the biosynthesis of mannose and Cordyceps polysaccharides (CP), and its upregulation significantly enhances CP production. Yang et al. [30] validated, through HiSeq2500 transcriptomic analysis and qRT-PCR, that many genes involved in polysaccharide biosynthesis in Poria cocos encode key enzymes related to polysaccharide synthesis, including malZ, galA, SORD, gnl, and bglX. These findings suggest that omics analysis may be a feasible approach for uncovering the genes and key enzymes associated with intracellular polysaccharide production in I. obliquus.
This study represents the first utilization of the ARTP technique to induce protoplast mutation and screening for high polysaccharide-producing mutants in I. obliquus. Whole-genome resequencing and comparative analysis were performed on the high-producing mutants and the parental strain to elucidate the biosynthetic pathways and functional genes associated with polysaccharide overproduction in I. obliquus. This research lays the foundation for the rational regulation of polysaccharide synthesis and the cultivation of high-quality strains of I. obliquus.
2. Materials and Methods
2.1. Liquid Fermentation and Polysaccharide Determination
Stain HS819 of I. obliquus was provided by the Institute of Microbiology, Xinjiang Academy of Agricultural Sciences. Four 1 cm diameter mycelial plugs of I. obliquus cultured on CYM agar plates (2 g peptone, 4 g yeast extract, 20 g glucose, 0.5 g MgSO4, 0.48 g K2HPO4, 0.5 g KH2PO4, and 16 g agar) for 15 days were transferred into a 50 mL centrifuge tube. After grinding, 5 mL of sterile water was added and mixed. The mixture was then inoculated into 100 mL of CYM seed culture medium (2 g peptone, 4 g yeast extract, 20 g glucose, 0.5 g MgSO4, 0.48 g K2HPO4, and 0.5 g KH2PO4) and cultivated at 30 °C with shaking at 150 rpm for 4 days. Subsequently, the seed culture was transferred into 100 mL of fermentation medium (25.0 g glucose, 7.0 g bran, 10.0 g soybean meal, 8.0 g corn powder, 4 g yeast powder, 1 g KH2PO4, 0.5 g MgSO4, pH 6) with an inoculum size of 10% and cultivated at 30 °C with shaking at 150 rpm for 10 days.
The mycelia were filtered from the fermentation broth using gauze, washed with distilled water until clear, dried at 50 °C to a constant weight, and then weighed. The dried mycelia were crushed, distilled water (solid–liquid ratio: 1:40) was added, it was ultrasonicated at 50 °C for 25 min and centrifuged at 2248× g for 10 min, and the supernatant was retained. We repeated the above steps three times [31]. The supernatants were combined, and we added anhydrous ethanol to a final concentration of 75%. Then, we let it sit at 4 °C for 12 h, centrifuged at 4500 r/min for 10 min, discarded the supernatant, and retained the precipitate. We dissolved the precipitate in distilled water and measured the polysaccharide concentration [32] as follows: Polysaccharide content = Total sugar content-Reducing sugar content. The total sugar content was determined using the phenol-sulfuric acid method [33], and reducing sugar content was determined using the DNS method [34].
2.2. Preparation and Regeneration of Protoplasts
The I. obliquus cultured on CYM solid plates was transferred using a cork borer to obtain four 1 cm diameter fungal disks, which were then transferred to 50 mL centrifuge tubes. After grinding, 5 mL of sterile water was added and mixed thoroughly. Subsequently, the mixture was inoculated into 100 mL CYM seed culture medium and incubated at 30 °C with shaking at 150 rpm for 6 d to obtain mycelia for protoplast preparation. Under aseptic conditions, mycelia from liquid fermentation were filtered through filter paper and washed with distilled water before being transferred to EP tubes, then 600 µL of 0.6 mol/L mannitol was added, and the mycelia were homogenized using a hand-held homogenizer. The homogenate was centrifuged at 11,100× g for 10 min to remove the mannitol, leaving behind the precipitate. The collected mycelial homogenate was incubated with a pretreatment solution (0.5% mercaptoethanol dissolved in 1.0 mol/L phosphate buffer, pH 6.0) for 30 min, with the untreated homogenate serving as a control. The lytic enzyme purchased from the Guangdong Institute of Microbiology was separately added to the two groups of mycelial homogenates at a final enzyme concentration of 30 mg/mL. Enzymatic digestion was carried out at 30 °C for 1.5 h. After completion of enzymatic digestion, residual mycelial fragments were removed using a G3 sand core shot funnel. The remaining mycelial fragments were repeatedly washed with 0.6 mol/L mannitol and filtered through a G3 sand core funnel to collect the filtrate for obtaining a high concentration of protoplasts. The filtrate was then centrifuged at 2248× g for 10 min, the supernatant was discarded, and the protoplasts were diluted with 0.6 mol/L mannitol and stored at 4 °C for future use. A 0.01% Calcofluor White aqueous solution was added to the protoplast suspension, and an observation was conducted using an S-Ri2 Nikon fluorescence microscope (×100) with a DAPI filter [35].
Using a hemocytometer, the protoplast concentration was adjusted to 1 × 106–1 × 107 cells/mL under a light microscope. Then, 0.1 mL of protoplast suspension was spread onto a CYM regeneration plate (containing 2 g peptone, 4 g yeast extract, 20 g glucose, 0.5 g MgSO4, 0.48 g K2HPO4, 0.5 g H2PO4, 16 g agar, and 109 g mannitol). The protoplasts spread on the CYM plates were used as the control. The regeneration of protoplasts was observed after incubating at 28 °C for 7–10 days.
Protoplast regeneration rate (%) = (Number of colonies on CYM regeneration plate − Number of colonies on CYM plate)/Number of protoplasts × 100%
2.3. ARTP Mutagenesis of Protoplasts and Screening of Mutant Strains
ARTP mutagenesis was performed using an ARTP mutagenesis system (Wuxi Yuanqingtianmu Biotechnology Co., Ltd., Wuxi, China). The operating parameters were as follows: the radio frequency power input was 120 W, the distance between the plasma torch nozzle exit and the sample plate was 2 mm, and the helium gas flow rate was 10 SLM (standard liter per minute). For the mutation, 20 µL of the protoplast suspension was dipped into the stainless-steel plate and then exposed to the ARTP jet for 0, 20, 40, 60, 80, 120, 140, 160, and 200s, respectively. Three replicates were performed for each time treatment. The treated metal discs were placed in EP tubes containing 500 µL of 0.6 mol/L mannitol and shaken thoroughly. Then, 200 µL of the shaken solution was spread onto CYM regeneration medium and incubated at 28 °C for 7–10 days. The optimal mutagenesis treatment time was determined based on the survival rate curve calculated as follows: (control colony count − surviving colony count)/control colony count × 100%.
The control colony count was the total colony count of the untreated sample and the surviving colony count was the total colony count after the ARTP treatment.
The mutated protoplasts were diluted and spread onto CYM regeneration plates. After 10 d, small colonies appeared on the plates. The colonies with a faster growth rate and thicker hyphae were selected and inoculated onto CYM plates for further culture. After 15 days, the strains were transferred to PDA slant tubes for preservation and inoculated into the CYM seed liquid. After 4 days, the strains with different growth characteristics compared to the wild strain were inoculated into the fermentation medium and cultured for 10 days to measure the mycelial polysaccharide concentration and the mycelial dry weight. The mycelial morphology and fermentation broth color were recorded by photographing the seed liquid on the 7th day of cultivation. The mutant strains with significantly increased polysaccharide production were selected for genetic stability testing. The mutant strains were subcultured on plates every 15 d for a total of five generations, and the polysaccharide concentration and mycelial dry weight were measured for each generation (1st, 2nd, 3rd, 4th, and 5th generations) using the aforementioned methods to determine the genetic stability of the mutant strains.
2.4. Genomic Sequencing Analysis
Strain HS819 and mutant strain A27 were cultured to logarithmic growth phase. Mycelia were collected by filtration on filter paper and stored at −80 °C for DNA extraction. The mycelia (2 g) were lysed with 1% SDS solution. Impurities in the lysate were removed using phenol/chloroform/isoamyl alcohol extraction, and genomic DNA was precipitated with isopropanol. The recovered DNA was checked using agarose gel electrophoresis and quantified using the Qubit 2.0 fluorometer (Thermo Scientific, Waltham, MA, USA). The genomes of strain HS819 and mutant strain A27 were sequenced using Illumina NovoSeq technology (Beijing Novogene Science and Technology Co., Ltd., Beijing, China).
The genomes of strains HS819 and A27 were assembled using the SOAP v2.21 software, and the genes were predicted using Genemark-ES. Annotation was performed using the NCBI non-redundant protein sequence database (NR), KEGG database, and CAZy database. The genomes of strains HS819 and A27 were aligned using BWA v0.7.17 software to identify the mutation sites. Insertion–deletion sites were detected using GATK v4.0.5.1software and annotated using ANNOVAR(2015Mar22) software.
2.5. Statistical Analyses
All statistical analyses were performed using one-way ANOVA (post hoc Tukey test) in IBM SPSS Statistics 24.0, with a p-value < 0.05, which was considered significant.
3. Results
3.1. Assessment of Protoplast Regeneration Ability
Protoplasts are components of living cells that are obtained by removing the cell wall through mechanical or enzymatic methods. Under enzymatic hydrolysis conditions, factors such as mycelial growth time, enzyme concentration, and hydrolysis time can affect the protoplast quantity and quality. This experiment utilized 6-day-old mycelia of HS819 as the raw material, with 0.6 mol/L mannitol as the osmotic stabilizer, and a chitinase concentration of 30 mg/mL. The enzymatic hydrolysis was conducted at 30 °C for 1.5 h. Under these conditions, the mycelia primarily released protoplasts laterally (Figure 1a), with large voluminous protoplasts containing nuclei (Figure 1b). Mercaptoethanol can break the disulfide bonds in cell wall proteins and disrupt the protein protective layer outside of the cell wall [36]. Post-treatment, there was no significant change in protoplast yield after enzymatic hydrolysis of the mycelial slurry. Fluorescent staining of protoplasts was performed using Calcofluor White. Most protoplasts exhibited incomplete cell wall rupture, emitting blue fluorescence around the cell periphery (Figure 1c). The protoplasts were plated on CYM solid culture medium to observe the colony size and count, and the protoplast regeneration rate was calculated to be approximately 5.83% (Figure 1d). The absence of visible colony formation on control plates indicated that the prepared protoplasts were free from mycelial contamination.
Figure 1.
Morphology and regeneration of protoplasts. (a) Lateral release of the protoplast; (b) Protoplast of I. obliquus; (c) Protoplast of I. obliquus stained with Calcofluor White. Scale bar = 20 µm. (d) The morphology of the colonies of regenerated protoplast in CYM regeneration media.
3.2. Determination of Protoplast Mutagenesis Conditions
Under ARTP mutagenesis conditions with a power of 120 W, airflow of 10 SLM, temperature of 30 °C, and treatment time of 0–200 s, the lethality of the protoplasts increased with the prolongation of ARTP mutagenesis time, and no cells survived at 200 s (Figure 2). Studies have shown that, in ARTP mutagenesis experiments, a lethal dose with a lethality rate close to 90% is usually selected, rather than the highest lethal dose [37]. Typically, a survival rate of 10–20% is favorable for obtaining more positive mutants [38]. Therefore, the optimal duration of mutagenesis for protoplasts was 140 s, which resulted in a lethality rate of 93% for the HS819 protoplasts.
Figure 2.
The relationship between mutagenesis time and lethality rate. The red dashed line indicates the treatment time selected for mutagenesis.
3.3. Screening of High-Yield Polysaccharide Mutants and Determination of Genetic Stability
Among the 160 regenerated strains obtained from mutagenesis, 32 strains exhibiting better growth compared to the wild strain in the CYM seed liquid medium were preliminarily selected for liquid fermentation. All 32 selected strains showed certain phenotypic changes compared to the wild strain, mainly in growth rate, mycelial morphology, color of the fermentation broth, and biomass. The morphology of the mycelial pellets of some mutant strains is shown in Figure 3. Compared to the wild-type strain, 13 mutant strains showed polysaccharide levels (Figure 4A) and 11 mutant strains exhibited biomass levels (Figure 4B) exceeding those of the starting strain by 10% (the red horizontal line represents the level of the original strain, while the red dashed line represents a 10% increase over the level of the original strain). Among them, mutant strain A27 had a polysaccharide content as high as 1.67 g/L and a biomass of 17.6 g/L, representing an increase of 137.67% and 15%, respectively, compared to the wild strain. Moreover, mutant strains B116, B160, B200, B32, and B96 showed more than a 50% increase in polysaccharide production compared to the wild strain, with B200 and B160 exhibiting 21.24% and 25.49% higher biomass, respectively. Six dominant strains (A27, B116, B160, B200, B32, and B96) with high polysaccharide production were selected using shake flask fermentation. After five consecutive subcultures, the polysaccharide content and biomass of each mutant strain were measured to verify the genetic stability.
Figure 3.
Morphology of mycelium pellets of some mutants.
Figure 4.
Mutant screening. (A) The yields of endo-polysaccharides of mutants. (B) The biomass of mutants. The red horizontal line represents the level of the original strain, whereas the red dashed line represents a 10% increase over the level of the original strain.
Through shake flask fermentation, six dominant strains (A27, B116, B160, B200, B32, and B96) producing polysaccharides were screened. After five consecutive subcultures of these strains, the polysaccharide production and biomass of each generation of HS819 mutant strains were measured to verify their genetic stability. During the consecutive subculture process, except for strains B200 and A27, the polysaccharide production of the other mutant strains had already returned to the level of the original strains by the fifth generation, with the fifth generation of strain A27 showing higher production than B200 (Figure 5A). The biosynthesis of polysaccharides is not only associated with the metabolic characteristics of the strain itself, but also positively correlated with the biomass of the mycelium. For mutant strain A27, its biomass remained stable during the subculture process, and its stability was superior to that of mutant strain B200 (Figure 5B). Taking all these factors into consideration, mutant strain A27 was chosen for further investigation into polysaccharides.
Figure 5.
Genetic stability of the mutants. (A) Yields of polysaccharides of the mutants; (B) Biomass of the mutants. Note: Different lowercase letters indicate significant differences between generations for the same strain (p < 0.05).
3.4. Growth and Metabolic Curves in Liquid Cultures of Wild Strain HS819 and Mutant Strain A27
The comparison of fermentation between wild strain HS819 and mutant strain A27 showed that, throughout the fermentation process, the trends in biomass and polysaccharide production of the two strains were similar, reaching their maximum values on the 10th day before entering a decline phase, with the mycelia undergoing autolysis (Figure 6). The polysaccharide concentration of mutant strain A27 began to increase rapidly from the 8th day, reaching 1.53 g/L at the end of fermentation, a 103.19% increase compared to the 0.753 g/L of the wild strain HS819. Additionally, the mutant strain exhibited a maximum biomass 20.5% higher than that of the wild strain, with biomass values of 16.93 g/L and 14.05 g/L, respectively. It is noteworthy that mutant strain A27 reached biomass levels equivalent to the wild strain on the 4th day of cultivation in the seed liquid, shortening the actual growth cycle by 2 days compared to the wild strain.
Figure 6.
Polysaccharide and mycelial biomass curves of strain HS819 and mutant strain A27 during liquid fermentation.
3.5. InDel Mining and Annotation of InDel Related to Polysaccharides Metabolism
Whole-genome resequencing was performed on wild strain HS819 and mutant strain A27. Compared to strain HS819, strain A27 had 3790 InDel mutations, including 2140 insertion mutations and 1650 deletion mutations (Table 1). In the CDS region, 204 InDel mutations were identified, including 127 frameshift mutations, 6 start codon mutations, 12 stop codon mutations, and 1 nonsense mutation, accounting for 1.891%, 0.089%, 0.179%, and 0.015% of the total CDS count, respectively. The remaining 0.864% of gene mutations had no significant impact on protein coding (Table 2). These InDel mutations involved 612 functional genes, and the mutation status and NR annotation results of the genes related to polysaccharides are shown in Table 3.
Table 1.
Statistics of the total number of InDel in the samples.
Table 2.
Statistics of the types of mutations caused by InDel in the CDS region.
Table 3.
Analysis of mutations in the polysaccharide-related differential gene of mutant strain A27 and NR annotation.
Most of the gene mutations related to carbohydrate metabolism in the NR annotation were also involved in the KEGG pathway associated with carbohydrate metabolism and CAZy clustering analysis, as follows: in the starch and sucrose metabolism pathway, the genes A2252, A3290, 6373, and A4713 of mutant strain A27 had mutations; and, in the glycolysis/gluconeogenesis pathway, the genes A6373, A1029, A3232, and A3715 had mutations. In addition, in the amino sugar nucleotide metabolism pathway, gene A6373 had mutations. The mutated A2408 and A4675 genes are involved in multiple pathways of N-glycan biosynthesis. In the interconversion pathway between mannose and glucuronic acid, gene A5969 had mutations. Furthermore, in the pentose phosphate pathway, gene A6373 had mutations. In the galactose metabolism pathway, the mutated gene was A4713, and, in other O-glycan biosynthesis pathways, gene A7152 had mutations (Table 4). The differential genes related to polysaccharide metabolism in the A27 mutant were also associated with glycoside hydrolases (GHs) activities, including A5969, A4713, A6734, A2408, A3290, A2252, and A3275. Gene A7545 was also associated with glycosyltransferases (GTs) activities (Table 5).
Table 4.
KEGG enrichment analysis of mutated genes associated with polysaccharide production in the mutants.
Table 5.
Analysis of CAZy data of mutated genes associated with polysaccharide production in mutant A27.
4. Discussion
The preparation and isolation of I. obliquus protoplasts are crucial for successful regeneration. In this study, 6-day-old HS819 mycelia were used as the raw material. The protoplast regeneration rate was approximately 5.83% using 0.6 mol/L mannitol as an osmotic stabilizer and 30 mg/mL of lytic enzyme at 30 °C for 1.5 h. Mercaptoethanol did not increase the enzymatic efficiency of the HS819 strain, which is consistent with the findings of Xu et al. [39], possibly due to the differences in cell wall composition, making it insensitive to mercaptoethanol. Although enzymatic hydrolysis is an effective method for protoplast preparation, steps such as filtration, washing, and low-speed centrifugation can lead to the loss and aggregation of suspended protoplasts, thereby affecting the final yield and regeneration rate of the protoplasts [23].
Xu et al. [40] reported a 37.7% increase in IPS1 and an 18.1% increase in IPS2 production 24 h after the addition of 0.1% (v/v) Tween 80, following the inoculation of I. obliquus. Wei et al. [41] achieved a 31% increase in mycelial polysaccharide production by implementing an integrated glucose titration and DO control strategy. Mutant strain JSU LIUK18, obtained through UV radiation mutagenesis, exhibited a 30.5% increase in mycelial polysaccharide compared to the wild-type strain [26]. These studies suggest that mycelial polysaccharide production in I. obliquus typically increases by approximately 30–50%, but the production efficiency still falls short of the market demand. This study, for the first time, utilized the atmospheric pressure and room temperature plasma (ARTP) mutagenesis breeding method with the original protoplasts of HS819 as the mutagenic material. Mutant strain A27 was selected from the mutagenized population with a cell death rate of 93%. Compared to parental strain HS819, mutant strain A27 showed a 137.67% increase in polysaccharides and a 15% increase in biomass. Additionally, the cultivation period was shortened from 14 days to 12 days, resulting in a significant improvement in production efficiency. ARTP technology has been widely used in bacterial, fungal, and microalgal mutagenesis to enhance productivity and improve characteristics [16,42,43]. Yang et al. [44] selected mutant 321 of Hericium erinaceus, with biomass increasing by 30.37% and intracellular polysaccharide content by 47.45%, compared to the original strain, using ARTP mutagenesis. Li et al. [45] screened a mutant of Sanghuangporus sanghuang via ARTP mutagenesis, wherein the average biomass of mutant strain A130 increased by 14.43%, compared with the original strain SH1, and the total polysaccharide contents of mutant strain A130 increased by 4.53%. Li et al. [46] used the protoplast of Ganoderma lucidum strain G0157 for ARTP treatment, obtaining mutant strain A-246, with the polysaccharide yield increasing by 268.57%, compared to the original strain. The results of this study are in accordance with previous studies, which have similarly reported the effective enhancement of polysaccharide production. These findings indicate that ARTP-mutagenesis-induced cellular genomic damage significantly alters the metabolic characteristics of the strain, particularly the polysaccharide production.
The increase in polysaccharide production of strain A27 may be attributed to the increase in biomass, the enhancement of polysaccharide-biosynthesis-related enzyme activities, and the upregulation of relevant gene expression levels. Genetic stability experiments have revealed that the mutation had some impact on the biomass of strain A27, but the increase in polysaccharide production was likely primarily caused by the other two factors. The mutated genes related to polysaccharide biosynthesis in the A27 strain included those encoding glucosylglucosephosphate mutase (A4175), phosphoglucoisomerase (A6373), glycosidase (A5969, A4173, A6734, A2408, A3290, A2252, and A3275), and glycosyltransferase (A7545). Among them, phosphoglucoisomerase (PGI) is involved in the pentose phosphate pathway, glycolysis/gluconeogenesis, and amino sugar and nucleotide sugar metabolism. Wang et al. [47] studied the biological function of PGI in Lentinula edodes and constructed a lepgi silencing strain using RNA interference technology, finding that the biomass of the lepgi silenced strain was significantly lower than that of the wild-type (WT) strain, and the levels of extracellular polysaccharides (EPS) and intracellular polysaccharides (IPS) increased by 1.5–3 times and 1.5 times, respectively. Phosphoglucomutase (PGM) is a key enzyme involved in polysaccharide synthesis, and some studies have shown that silencing the PGM gene is related to a decrease in extracellular polysaccharide production (about 20–40% of the WT strain) and an increase in intracellular polysaccharide production (about 1.7 times that of the WT strain) in Ganoderma lucidum [48]. Xu et al. [49] also showed that the overexpression of this gene can increase the maximum IPS content and EPS yield of G.lucidum by 40.5% and 44.3%, respectively. The GHs gene family regulates the high production of polysaccharides in G.lucidum. The expressed proteins (glycosidases) degrade the cell wall polysaccharides of hyphae, and some degraded polysaccharides are released into the culture medium, which is beneficial for the extraction of intracellular polysaccharides and can yield more extracellular polysaccharides [50]. Mannan polysaccharides are one of the components of fungal cell wall polysaccharides. The genome of strain A27 encodes genes for α-glucosidase (enzyme code ec3.2.1.20), α-galactosidase (enzyme code ec3.2.1.22), α-mannosidase (enzyme code ec3.2.1.113), β-glucosidase (enzyme code ec3.2.1.21), and β-galactosidase (enzyme code ec3.2.1.23), which are involved in the hydrolysis of the mannose skeleton, among which β-glucosidase and α-galactosidase are key enzymes in mannose skeleton hydrolysis [51]. The GTs gene family promotes the assembly of polysaccharides, and glycosyltransferases catalyze the continuous transfer of sugars from specific activated donors to specific receptor molecules, thereby forming region-specific and stereo-specific glycosidic bonds [52].
This study utilized ARTP and genome resequencing technology to analyze gene mutations related to high polysaccharide production in I. obliquus. The predicted polysaccharide-related mutated genes and specific mutated genes related to high polysaccharide production were analyzed. Further investigations should focus on changes at the transcriptional, expression, and metabolic levels to comprehensively elucidate that ARTP promotes high polysaccharide production in I. obliquus, providing valuable insights for obtaining high-yield, stable strains through genetic engineering and breeding.
Author Contributions
Conceptualization, K.L. and X.H.; formal analysis, L.H. and H.S.; validation, L.H. and H.S.; writing—original draft, L.H., H.S. and X.H.; writing—review and editing, X.H. and K.L.; investigation, L.H., H.S., H.W., Y.G. and J.Z.; funding acquisition, K.L., X.H. and Q.L.; supervision, K.L., X.H. and Q.L. All authors have read and agreed to the published version of the manuscript.
Funding
This work was funded by the Construction Plan of Science and Technology Innovation Base of Xinjiang Uygur Autonomous Region (Open Project of Key Laboratory, grant no. 2023D04057) and the Project of Fund for Stable Support to Agricultural Sci-Tech Renovation (grant no. xjnkywdzc-2023005-6).
Data Availability Statement
Dataset available upon request from the authors.
Acknowledgments
We acknowledge Jinyu Li for his creative contribution in assisting with this investigation.
Conflicts of Interest
The authors declare that they do not have any competing interests.
References
- Ma, L.; Chen, H.; Zhang, Y.; Zhang, N.; Fu, L. Chemical modification and antioxidant activities of polysaccharide from mushroom Inonotus obliquus. Carbohydr. Polym. 2012, 89, 371–378. [Google Scholar] [CrossRef] [PubMed]
- Jiang, S.; Shi, F.; Lin, H.; Ying, Y.; Luo, L.; Huang, D.; Luo, Z. Inonotus obliquus polysaccharides induces apoptosis of lung cancer cells and alters energy metabolism via the LKB1/AMPK axis. Int. J. Biol. Macromol. 2020, 151, 1277–1286. [Google Scholar] [CrossRef]
- Su, L.; Xin, C.; Yang, J.; Dong, L.; Mei, H.; Dai, X.; Wang, Q. A polysaccharide from Inonotus obliquus ameliorates intestinal barrier dysfunction in mice with type 2 diabetes mellitus. Int. J. Biol. Macromol. 2022, 214, 312–323. [Google Scholar] [CrossRef] [PubMed]
- Hu, B.; Dong, Y.; Zhou, W.; Ma, Y.; Li, L.; Fu, X.; Zhang, W.; Luo, Y.; Pu, J.; Deng, X.; et al. Effect of Inonotus obliquus polysaccharide on composition of the intestinal flora in mice with acute endometritis. PLoS ONE 2021, 16, e0259570. [Google Scholar] [CrossRef]
- Hu, Y.; Sheng, Y.; Yu, M.; Li, K.; Ren, G.; Xu, X.; Qu, J. Antioxidant activity of Inonotus obliquus polysaccharide and its amelioration for chronic pancreatitis in mice. Int. J. Biol. Macromol. 2016, 87, 348–356. [Google Scholar] [CrossRef]
- Zhang, C.J.; Guo, J.Y.; Cheng, H.; Li, L.; Liu, Y.; Shi, Y.; Xu, J.; Yu, H.T. Spatial structure and anti-fatigue of polysaccharide from Inonotus obliquus. Int. J. Biol. Macromol. 2020, 151, 855–860. [Google Scholar] [CrossRef] [PubMed]
- Teplyakova, T.V.; Ilyicheva, T.N.; Kosogova, T.A.; Wasserb, S.P. Medicinal Mushrooms against Influenza Viruses. Int. J. Med. Mushrooms 2021, 23, 1–11. [Google Scholar] [CrossRef] [PubMed]
- He, H.; Li, Y.; Fang, M.; Li, T.; Liang, Y.; Mei, Y. Carbon Source Affects Synthesis, Structures, and Activities of Mycelial Polysaccharides from Medicinal Fungus Inonotus obliquus. J. Microbiol. Biotechnol. 2021, 31, 855–866. [Google Scholar] [CrossRef] [PubMed]
- Wang, M.; Zhao, Z.; Zhou, X.; Hu, J.; Xue, J.; Liu, X.; Zhang, J.; Liu, P.; Tong, S. Simultaneous use of stimulatory agents to enhance the production and hypoglycaemic activity of polysaccharides from Inonotus obliquus by submerged fermentation. Molecules 2019, 24, 4400. [Google Scholar] [CrossRef]
- Chen, H.J.; Chen, Y.S.; Liu, S.L.; Liou, B.K.; Chen, C.S. The influence of submerged fermentation of Inonotus obliquus with control atmosphere treatment on enhancing bioactive ingredient contents. Appl. Biochem. Biotech. 2020, 191, 412–425. [Google Scholar] [CrossRef]
- Yu, Q.; Li, Y.; Wu, B.; Hu, W.; He, M.; Hu, G. Novel mutagenesis and screening technologies for food microorganisms: Advances and prospects. Appl. Microbiol. Biotechnol. 2020, 104, 1517–1531. [Google Scholar] [CrossRef] [PubMed]
- Abrol, V.; Kushwaha, M.; Mallubhotla, S.; Jaglan, S. Chemical mutagenesis and high throughput media optimization in Tolypocladium inflatum MTCC-3538 leads to enhanced production of cyclosporine A. 3 Biotech 2022, 12, 158. [Google Scholar] [CrossRef] [PubMed]
- Xie, M.; Li, Q.; Hu, X.-P.; Zhang, Y.-J.; Peng, D.-L.; Zhang, X.-L. Effects of a NTG-based chemical mutagenesis on the propamocarb-tolerance of the nematophagous fungus Lecanicillium attenuatum. Pestic. Biochem. Physiol. 2017, 141, 71–75. [Google Scholar] [CrossRef] [PubMed]
- Lotfy, W.A.; Ghanem, K.M.; El-Helow, E.R. Citric acid production by a novel Aspergillus niger isolate: I. Mutagenesis and cost reduction studies. Bioresour. Technol. 2007, 98, 3464–3469. [Google Scholar] [CrossRef] [PubMed]
- Zhao, S.; Tan, M.Z.; Wang, R.X.; Ye, F.T.; Chen, Y.P.; Luo, X.M.; Feng, J.X. Combination of genetic engineering and random mutagenesis for improving production of raw-starch-degrading enzymes in Penicillium oxalicum. Microb. Cell Factories 2022, 21, 272. [Google Scholar] [CrossRef]
- Ottenheim, C.; Nawrath, M.; Wu, J.C. Microbial mutagenesis by atmospheric and room-temperature plasma (ARTP): The latest development. Bioresour. Bioprocess. 2018, 5, 12. [Google Scholar] [CrossRef]
- Zhang, X.; Zhang, X.-F.; Li, H.-P.; Wang, L.-Y.; Zhang, C.; Xing, X.-H.; Bao, C.-Y. Atmospheric and room temperature plasma (ARTP) as a new powerful mutagenesis tool. Appl. Microbiol. Biotechnol. 2014, 98, 5387–5396. [Google Scholar] [CrossRef]
- Zhang, H.; Jiang, F.; Qu, D.; Wang, W.; Dong, Y.; Zhang, J.; Wu, D.; Yang, Y. Employment of ARTP to generate Phellinus baumii (Agaricomycetes) strain with high flavonoids production and validation by liquid fermentation. Int. J. Med. Mushrooms 2019, 21, 1207–1221. [Google Scholar] [CrossRef]
- Liu, W.; Yang, W.; Wu, J.; Cheng, Y.; Wei, Z.; Wang, T.; Ampofo, K.A.; Ma, H.; Cui, F.; Yang, X.; et al. ARTP Mutagenesis to Improve Mycelial Polysaccharide Production of Grifola frondosa Using a Mixture of Wheat Bran and Rice Bran as Substrate. J. Food Qual. 2021, 2021, 6110743. [Google Scholar] [CrossRef]
- Cao, S.; Zhou, X.; Jin, W.; Wang, F.; Tu, R.; Han, S.; Chen, H.; Chen, C.; Xie, G.-J.; Ma, F. Improving of lipid productivity of the oleaginous microalgae Chlorella pyrenoidosa via atmospheric and room temperature plasma (ARTP). Bioresour. Technol. 2017, 244, 1400–1406. [Google Scholar] [CrossRef]
- Fang, M.; Jin, L.; Zhang, C.; Tan, Y.; Jiang, P.; Ge, N.; Li, H.; Xing, X. Rapid mutation of Spirulina platensis by a new mutagenesis system of atmospheric and room temperature plasmas (ARTP) and generation of a mutant library with diverse phenotypes. PLoS ONE 2013, 8, e77046. [Google Scholar] [CrossRef] [PubMed]
- Zhang, X.; Zhang, C.; Zhou, Q.-Q.; Zhang, X.-F.; Wang, L.-Y.; Chang, H.-B.; Li, H.-P.; Oda, Y.; Xing, X.-H. Quantitative evaluation of DNA damage and mutation rate by atmospheric and room-temperature plasma (ARTP) and conventional mutagenesis. Appl. Microbiol. Biotechnol. 2015, 99, 5639–5646. [Google Scholar] [CrossRef] [PubMed]
- Zhang, Z.; Shah, A.M.; Mohamed, H.; Zhang, Y.; Sadaqat, B.; Tsiklauri, N.; Sadunishvili, T.; Song, Y. Improved laccase production in Pleurotus djamor RP by atmospheric and room temperature plasma (ARTP) mutagenesis. Electron. J. Biotechnol. 2022, 58, 1–9. [Google Scholar] [CrossRef]
- Liang, L.; Huang, Q.; Weng, X.; Wu, S.; Huang, J. Breeding L-Glutamic Acid Producing Engineering Strain by Mutagenesis and Its Fermentation Efficiency. Biotechnol. Bull. 2020, 36, 143–149. [Google Scholar] [CrossRef]
- Cen, Y.-K.; Li, M.; Wang, Q.; Zhang, J.-M.; Yuan, J.-C.; Wang, Y.-S.; Liu, Z.-Q.; Zheng, Y. Evolutionary engineering of Fusarium fujikuroi for enhanced production of gibberellic acid. Process Biochem. 2023, 125, 7–14. [Google Scholar] [CrossRef]
- Ampofo, K.A. Study on Mutagenesis and Liquid Fermentation of Inonotus Obliquus with Rice Bran and Wheat Bran. Master’s Thesis, Jiangsu University, Zhenjiang, China, 2019. [Google Scholar]
- Gong, M.; Zhang, H.; Wu, D.; Zhang, Z.; Zhang, J.; Bao, D.; Yang, Y. Key metabolism pathways and regulatory mechanisms of high polysaccharide yielding in Hericium erinaceus. BMC Genom. 2021, 22, 160. [Google Scholar] [CrossRef] [PubMed]
- Wu, T.; Cai, M.; Hu, H.; Jiao, C.; Zhang, Z.; Liu, Y.; Chen, J.; Xiao, C.; Li, X.; Gao, X.; et al. Whole-Genome Sequencing and Transcriptome Analysis of Ganoderma lucidum Strain Yw-1-5 Provides New Insights into the Enhanced Effect of Tween80 on Exopolysaccharide Production. J. Fungi 2022, 8, 1081. [Google Scholar] [CrossRef]
- Lin, S.; Liu, Z.-Q.; Baker, P.J.; Yi, M.; Wu, H.; Xu, F.; Teng, Y.; Zheng, Y.-G. Enhancement of cordyceps polysaccharide production via biosynthetic pathway analysis in Hirsutella sinensis. Int. J. Biol. Macromol. 2016, 92, 872–880. [Google Scholar] [CrossRef]
- Yang, L.; Tang, J.; Chen, J.-J.; Peng, A.-Y.; Wang, Q.-M.; Rao, L.-Q.; Yang, H.; Zhang, X.-W.; Yang, H.-Z.; Zhang, C. Transcriptome analysis of three cultivars of Poria cocos reveals genes related to the biosynthesis of polysaccharides. J. Asian Nat. Prod. Res. 2019, 21, 462–475. [Google Scholar] [CrossRef]
- Wang, J.; Yang, Z.; Liu, T.; Shen, S.; Chen, X.; Qin, W.; Wang, L.; Wan, L. Extraction Process Optimization and Antioxidant Ability Evaluation of Inonotus obliquus Polysaccharide. Food Nutr. China 2017, 23, 46–49. [Google Scholar]
- Pang, C.L. Production of Inonotus obliquus Mycelium by Submerged Fermentation and Analysis on Its Active Ingredients. Master’s Thesis, Jiangnan University, Wuxi, China, 2008. [Google Scholar]
- Masuko, T.; Minami, A.; Iwasaki, N.; Majima, T.; Nishimura, S.-I.; Lee, Y.C. Carbohydrate analysis by a phenol–sulfuric acid method in microplate format. Anal. Biochem. 2005, 339, 69–72. [Google Scholar] [CrossRef]
- Hu, R.; Lin, L.; Liu, T.; Ouyang, P.; He, B.; Liu, S. Reducing sugar content in hemicellulose hydrolysate by DNS method: A revisit. J. Biobased Mater. Bioenergy 2008, 2, 156–161. [Google Scholar] [CrossRef]
- Huddy, S.M.; Meyers, A.E.; Coyne, V.E. Protoplast isolation optimization and regeneration of cell wall in Gracilaria gracilis (Gracilariales, Rhodophyta). J. Appl. Phycol. 2013, 25, 433–443. [Google Scholar] [CrossRef]
- Peberdy, J.F. Fungal protoplasts: Isolation, reversion, and fusion. Annu. Rev. Microbiol. 1979, 33, 21–39. [Google Scholar] [CrossRef] [PubMed]
- Xiang, J.; Yang, Y.; Dabbour, M.; Mintah, B.K.; Zhang, Z.; Dai, C.; He, R.; Huang, G.; Ma, H. Metabolomic and genomic profiles of Streptomyces albulus with a higher ε-polylysine production through ARTP mutagenesis. Biochem. Eng. J. 2020, 162, 107720. [Google Scholar] [CrossRef]
- Nie, X.; Xing, Y.; Li, Q.; Gao, F.; Wang, S.; Liu, P.; Li, X.; Tan, Z.; Wang, P.; Shi, H. ARTP mutagenesis promotes selenium accumulation in Saccharomyces boulardii. LWT 2022, 168, 113916. [Google Scholar] [CrossRef]
- Xu, F.; Tao, W.Y.; Cheng, L.; Guo, L.J. Formation and Regeneration of Protoplasts of Taxol-Producing Endophytic Fungus Fusarium maire. J. Food Sci. Biotechnol. 2006, 25, 20–24. [Google Scholar]
- Xu, X.; Quan, L.; Shen, M. Effect of chemicals on production, composition and antioxidant activity of polysaccharides of Inonotus obliquus. Int. J. Biol. Macromol. 2015, 77, 143–150. [Google Scholar] [CrossRef]
- Wei, Z.-H.; Chen, N.; Li, Y.-J.; Fan, Q.-L.; Yu, T.-F.; Wang, K.-X.; Dong, B.-T.; Fan, E.-Y.; Yuan, P.-L.; Hu, G.-W. Glucose fed-batch integrated dissolved oxygen control strategy enhanced polysaccharide, total triterpenoids and inotodiol production in fermentation of a newly isolated Inonotus obliquus strain. Process Biochem. 2018, 66, 1–6. [Google Scholar] [CrossRef]
- Zhang, Q.; Miao, R.; Feng, R.; Yan, J.; Wang, T.; Gan, Y.; Zhao, J.; Lin, J.; Gan, B. Application of Atmospheric and Room-Temperature Plasma (ARTP) to Microbial Breeding. Curr. Issues Mol. Biol. 2023, 45, 6466–6484. [Google Scholar] [CrossRef]
- Dong, Y.; Miao, R.; Feng, R.; Wang, T.; Yan, J.; Zhao, X.; Han, X.; Gan, Y.; Lin, J.; Li, Y.; et al. Edible and medicinal fungi breeding techniques, a review: Current status and future prospects. Curr. Res. Food Sci. 2022, 5, 2070–2080. [Google Scholar] [CrossRef] [PubMed]
- Yang, S.; Yang, Y.; Li, Q.; Wu, D.; Yang, R.; Wang, W.; Zhang, H. Screening of high-yield polysaccharide Hericium erinareus by atmospheric and room temperature plasma mutagenesis. Acta Agric. Shanghai 2019, 35, 7–11. [Google Scholar]
- Li, T.; Chen, L.; Wu, D.; Dong, G.; Chen, W.; Zhang, H.; Yang, Y.; Wu, W. The Structural Characteristics and Biological Activities of Intracellular Polysaccharide Derived from Mutagenic Sanghuangporous sanghuang Strain. Molecules 2020, 25, 3693. [Google Scholar] [CrossRef] [PubMed]
- Li, Y.; Zhang, H.; Tan, Y.; Liu, Y.; Feng, J.; Zhang, Y.; Tang, C.; Zhang, J. Screening of a High Polysaccharide Content Ganoderma lucidum Strain by ARTP. Acta Edulis Fungi 2021, 37, 36–41. [Google Scholar] [CrossRef]
- Wang, Y.; Chen, J.; Han, J.; Yang, Z.; Zhu, J.; Ren, A.; Shi, L.; Yu, H.; Zhao, M. Cloning and characterization of phosphoglucose isomerase in Lentinula edodes. J. Basic Microbiol. 2022, 62, 740–749. [Google Scholar] [CrossRef] [PubMed]
- Hu, Y.; Li, M.; Wang, S.; Yue, S.; Shi, L.; Ren, A.; Zhao, M. Ganoderma lucidum phosphoglucomutase is required for hyphal growth, polysaccharide production, and cell wall integrity. Appl. Microbiol. Biotechnol. 2018, 102, 1911–1922. [Google Scholar] [CrossRef] [PubMed]
- Xu, J.W.; Ji, S.L.; Li, H.J.; Zhou, J.S.; Duan, Y.Q.; Dang, L.Z.; Mo, M.H. Increased polysaccharide production and biosynthetic gene expressions in a submerged culture of Ganoderma lucidum by the overexpression of the homologous α-phosphoglucomutase gene. Bioprocess Biosyst. Eng. 2015, 38, 399–405. [Google Scholar] [CrossRef]
- Wang, Q.; Xu, M.; Zhao, L.; Chen, L.; Ding, Z. Novel Insights into the Mechanism Underlying High Polysaccharide Yield in Submerged Culture of Ganoderma lucidum Revealed by Transcriptome and Proteome Analyses. Microorganisms 2023, 11, 772. [Google Scholar] [CrossRef] [PubMed]
- Singh, S.; Singh, G.; Arya, S.K. Mannans: An overview of properties and application in food products. Int. J. Biol. Macromol. 2018, 119, 79–95. [Google Scholar] [CrossRef]
- Schuman, B.; Alfaro, J.A.; Evans, S.V. Glycosyltransferase Structure and Function. Bioact. Conform. I 2007, 272, 217–257. [Google Scholar] [CrossRef]
Disclaimer/Publisher’s Note: The statements, opinions and data contained in all publications are solely those of the individual author(s) and contributor(s) and not of MDPI and/or the editor(s). MDPI and/or the editor(s) disclaim responsibility for any injury to people or property resulting from any ideas, methods, instructions or products referred to in the content. |
© 2024 by the authors. Licensee MDPI, Basel, Switzerland. This article is an open access article distributed under the terms and conditions of the Creative Commons Attribution (CC BY) license (https://creativecommons.org/licenses/by/4.0/).